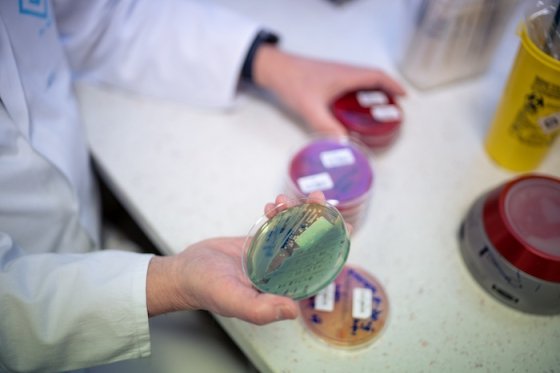
/media/23006/antibiotickarezistence-cz

# Aktuality # Reklama # Marketing
Pilulka mění brand identitu i směřování značky
Značka Pilulka prochází kompletní transformací. Z online lékárny se
mění v digitální platformu pro zdravotní prevenci a dlouhověkost.

# Aktuality # Reklama # Marketing
Značka Pilulka prochází kompletní transformací. Z online lékárny se
mění v digitální platformu pro zdravotní prevenci a dlouhověkost.

Součástí letošní kampaně společnosti Estée Lauder na podporu povědomí
o rakovině prsu je také růžové nasvícení žižkovské
televizní věže.

Růžový slon přichází s kampaní „Pink Power“, za každý nákup
daruje třicet korun na prevenci závažných onemocnění.

Díky analýze odpadních vod přichází Česká asociace pojišťoven
s kampaní, jež varuje řidiče tam, kde je to potřeba.

# Aktuality # Marketing # Reklama
V prvním čtvrtletí příštího roku odstartuje Dr. Max preventivní projekt
DiaTour, ambasadorem je zpěvák a herec Petr Kutheil.

Myslíme si, že do zdraví nemusíme investovat vůli, peníze ani čas,
říká Aziz Jahić ze skupiny EUC, jež stojí za kampaní „Zdraví
nazdar”.

# Aktuality # Reklama # Marketing
Na trh vstupuje Terrapino, aplikace, která uživatelům denně předkládá
nové úkoly k udržení mentální a fyzické kondice.
Státní zdravotní ústav spouští další vlnu své edukační kampaně,
v níž upozorňuje na nadužívání antibiotik.

Nová kampaň Movember upozorňuje na prevenci rakoviny prostaty a varlat.

Hartmann-Rico se v kampani spojuje se záchranářem MUDr. Markem Dvořákem.
Chce upozornit na problémy se srdcem.